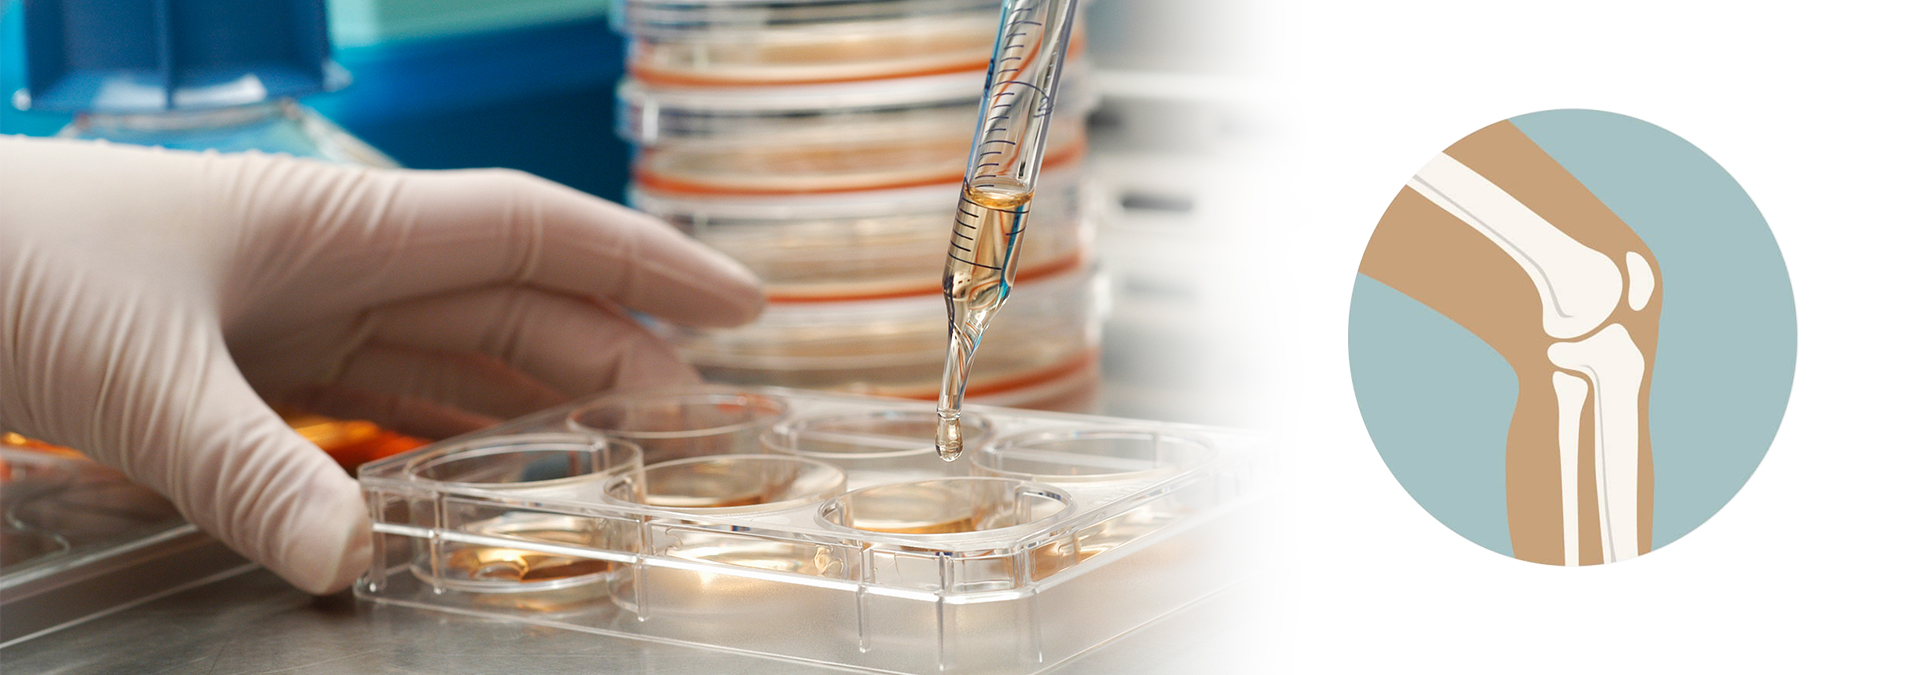

产品展示
技术支持
新闻中心
-
292024-07抗原抗体反复冻融不稳定的原因及解决思路一下文章来源于IVD研发宝,作者研发没烦恼Hello啊,宝子们!上期内容我们对最近1个多月的《干货》进行了总结,本期内容给大家讲讲抗原抗体反复冻融不稳定的原因及...
-
112020-08药物I期临床试验中受试者权益保护的思考来源:医药导报 2016 年 8 月第 35 卷 [摘要]该文强调在I期临床试验中医学伦理学的相关注意事项。在I期临床试验开始前,研究者要协助申办者充分全面评估...
-
102020-08综述:EGFR 单克隆抗体改善部分进展期非小细胞肺根据肿瘤的分子特征进行靶向治疗,为进展期非小细胞肺癌(nonsmall cell lung cancer,NSCLC)患者的治疗提供了新机会。85% 的 NSC...
-
102020-08他们是志愿者,更是无名英雄!来源: 北京晚报 2017年01月17日 一种新药,从实验室到最终上市,必须要经过健康人体试验的过程,这就是一期临床试验。这些健康的志愿者到底是在什么样的环境下...
-
102020-08【招募患者】IBI301治疗B细胞淋巴瘤临床试验受试者招募 信达生物制药(苏州)有限公司发起的比较重组人鼠嵌合 抗CD20 单克隆抗体注射液 (IBI301) 与原研药利妥昔单抗注射液在 CD20 阳性 B ...
公司简介
| 湖南郴新生物技术有限公司坐落于粤港澳后花园湖南郴州国家级高新区创新创业园,公司致力于体外诊断试剂(IVD)核心原材料的研发、制备及销售。 公司在IVD核心原材料的研发、制备上已经积累沉淀了10余年,公司一直秉承客户至上,质量第一的宗旨服务体外诊断试剂厂家,迄今为止公司研发的部分原料,灵敏度和特异性方面都赶上了国际先进水平,让国内的部分IVD厂家能够用上国产的质优价廉的原... ... |
公司简介
湖南郴新生物技术有限公司坐落于粤港澳后花园湖南郴州国家级高新区创新创业园,公司致力于体外诊断试剂(IVD)核心原材料的研发、制备及销售。 公司在IVD核心原材料的研发、制备上已经积累沉淀了10余年,公司一直秉承客户至上,质量第一的宗旨服务体外诊断试剂厂家,迄今为止公司研发的部分原料,灵敏度和特异性方面都赶上了国际先进水平,让国内的部分IVD厂家能够用上国产的质优价廉的原......
more